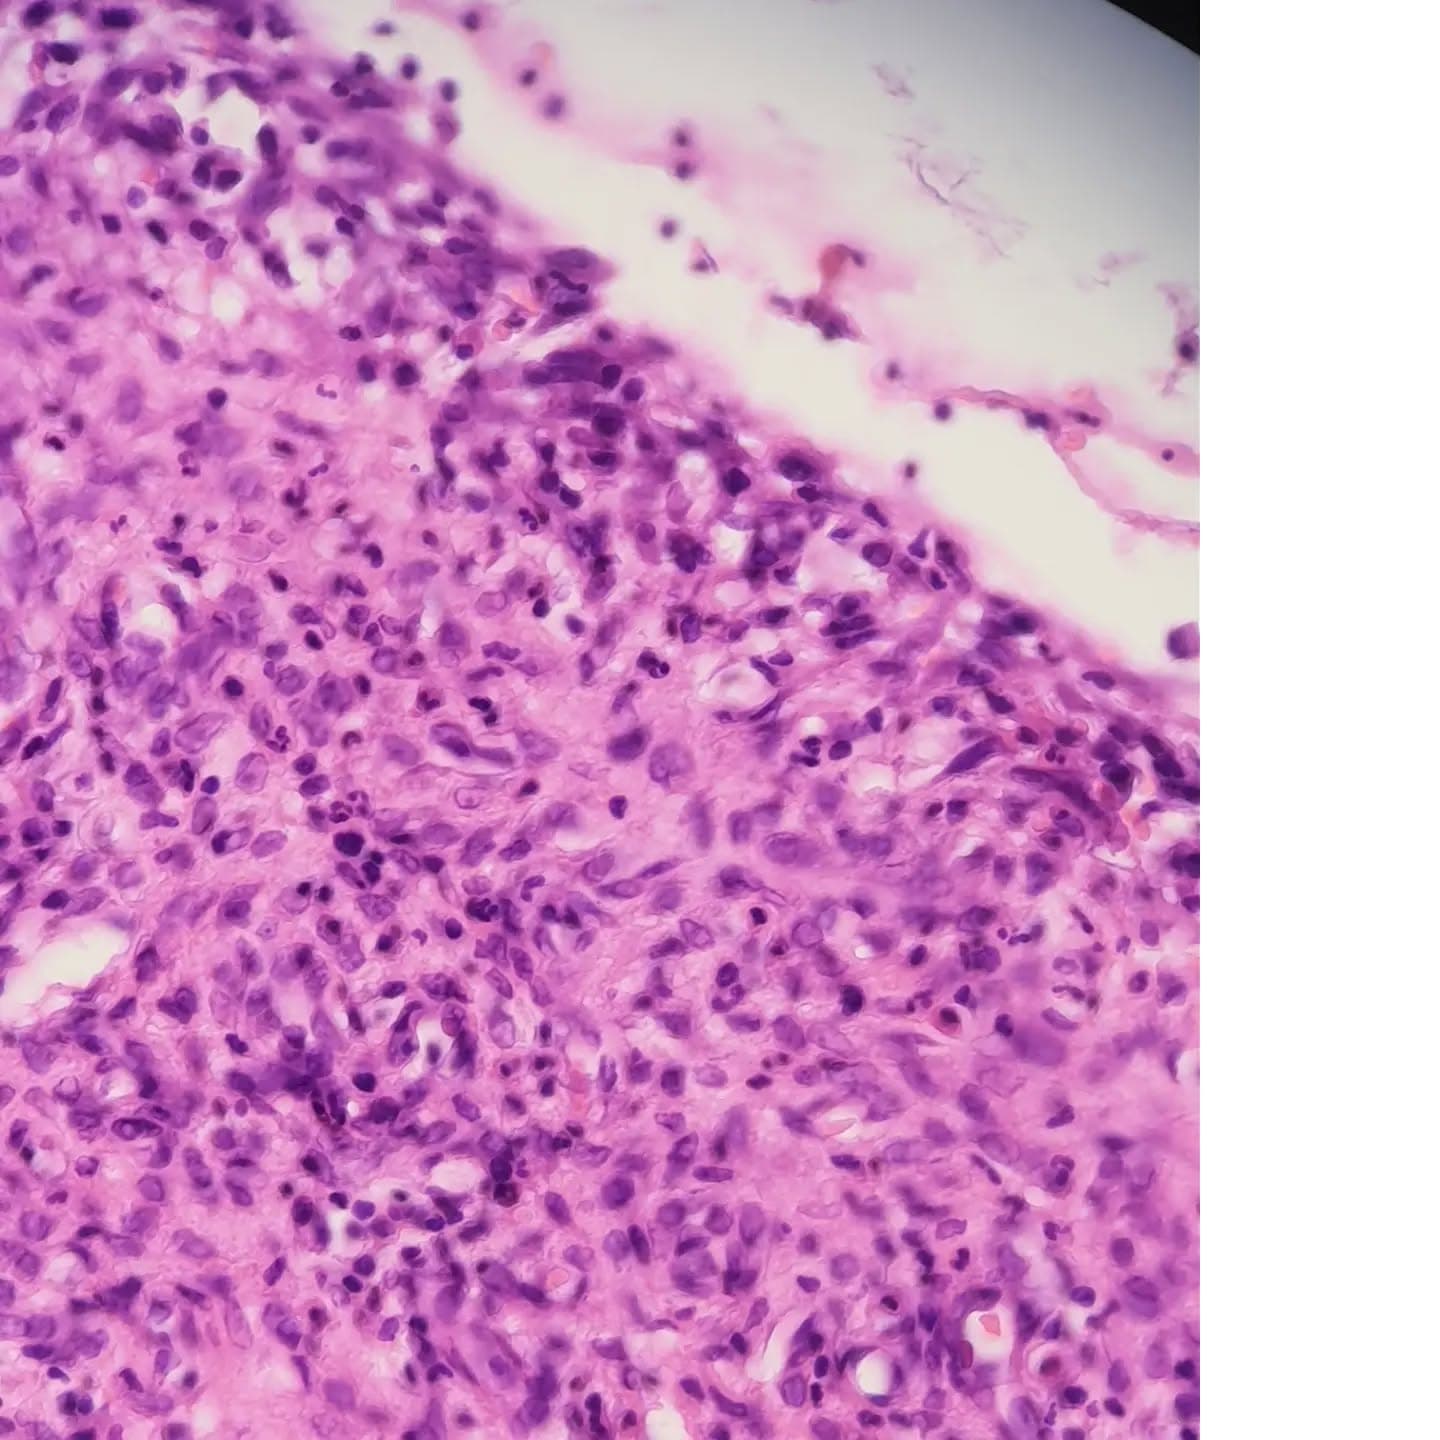
An 11 y/o male with a lower lip lesion
A cyst like structure lined by abundant foamy histiocytes and neutrophils.
The adjacent salivary gland shows lymphoplasmacytic infiltrate and ductal dilation.
Dx: mucous cyst (mucocele)

Back to Posts March 5, 2023
March 5, 2023
Photo 1 of 10
professionaly/omale
Caption: An 11 y/o male with a lower lip lesion A cyst like structure lined by abundant foamy histiocytes and neutrophils. The adjacent salivary gland shows lymphoplasmacytic infiltrate and ductal dilation. Dx: mucous cyst (mucocele)